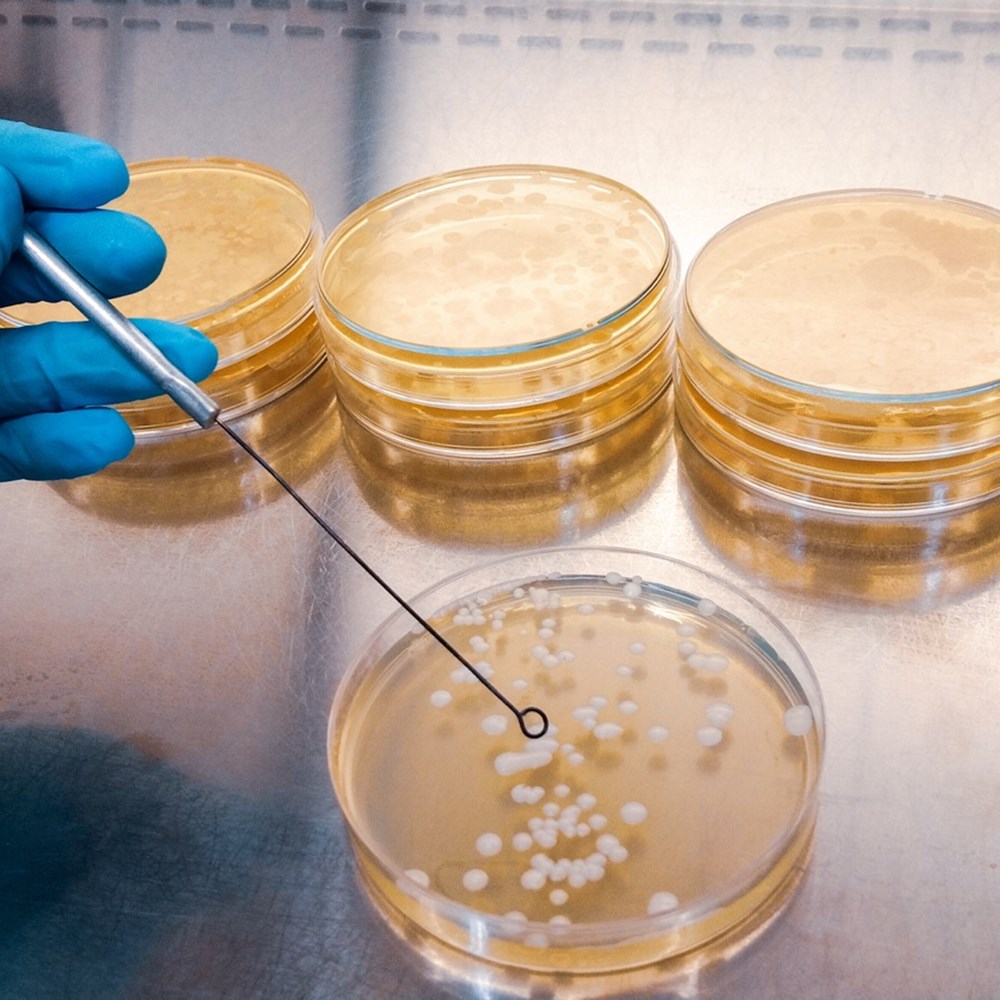

Digital Dairy Chain
Transforming the Dairy Supply Chain with Innovation, Collaboration, and Growth.


Project summary
The Digital Dairy Chain offers any business or individual involved in the dairy supply chain across Cumbria, South and West Scotland a range of services to support innovation and productivity through collaboration.
It is a five-year, UK Research & Innovation funded project with a budget of £21 million to transform the dairy sector in the region and uplift the rural economy, via grant funding and sustainable solutions.
The project is focused on aligning industry needs including developing digital connectivity, stimulating research and new product development, supporting business growth and attracting talent and skills, across the region.
It aims to put the region on the world map as a leader in advanced, sustainable, and digitally connected dairy manufacturing by offering farmers, processors, producers, and anyone else involved in the dairy supply chain a hub of support, funding, and business development opportunities as well as access to ground-breaking research, innovative technology, and industry expertise.


Objectives
Over a 5-year period, the project aims to:
- Develop Digital Connectivity - Utilising advanced technology & research to add value and connect the sector in the region.
- Stimulate Research & Development - Provide the infrastructure and expertise to enable collaborative R&D projects.
- Facilitate Business Growth - For early ventures, scale-up businesses, and established companies to undertake New Product Development and process improvement.
- Attract Talent & Skills - Showcase the industry and create opportunities for new talent to discover the range of roles within modern dairying.

Project Initiatives Summaries
Digital Dairy Chain will deliver its ambitious objectives through eight overlapping project initiatives:

Supply Chain Digitisation
Through a collaboration between the dairy industry and academic partners, a first-of-a-kind ‘Digitalisation Demonstrator’ is being created. Connecting the whole dairy supply chain from grass to glass the collaborators are developing new technologies to address the challenges faced by the dairy sector.

Innovation Brokers
Innovation Brokers are here to work alongside any business involved in the dairy supply chain to understand your challenges and to help you find or develop the right solutions. Funding exists through Innovation Vouchers which encourage partnerships between a business or start-up and a university for an innovation project. Projects must be a novel/pioneering idea and lead to new products, processes, or services that will benefit the sector.
Collaborative R&D and Growth Funding Competition
Collaborative innovation grants of up to £3 million will be made available to UK registered businesses operating in the dairy sector or the enabling technology industries (e.g., robotics, sensors, advanced manufacturing). Projects should be undertaken in Cumbria; South or West Scotland and project outputs should be exploited in the region.

Transformational Dairy Research
Businesses will be able to access expertise and facilities through Dairy Nexus, a new state-of-the-art co-innovation hub based at SRUC’s Barony Campus in Dumfries. The Digital Dairy Chain project will work in tandem with research activity and will focus on innovation in on-farm and downstream milk processing technologies. The aim is to maximise the value of milk and reduce energy consumption and waste in processing and storage.

Maker Spaces
The ‘Maker Spaces’ in Cumbria and Ayrshire will give producers of dairy products and dairy-based food and drink the chance to develop new products or move from small-scale ‘kitchen creations’ into commercially viable production, with mentorship and training opportunities.

Milk Round Accelerator
This initiative supports individuals and SMEs with technology ideas that could improve efficiency in the dairy sector, reduce its environmental impact or help it to meet net zero targets. The programme offers hands-on technical, engineering and business support to help develop your concept and fast-track it to demonstration and testing.

STEM Engagement
Engaging with young people across the region to highlight the range of STEM (Science, Technology, Engineering and Mathematics) jobs available in the dairy industry and develop a long-term pipeline of talent for the sector. We organise and host events with the aim of inspiring and engaging young people aged 10-14. Our events bring together industry, further education establishments and schools under one roof.

Workforce for the Future
A review of anticipated skills needs across next 10-25 years for the dairy supply chain will be undertaken. This will involve wide-reaching consultation across the whole value chain; connecting partners and beneficiaries of this project with the education/training providers and existing skills programmes in the region.

Meet our team
Read all about the team behind this great project on the Digital Dairy Chain website.
Digital Dairy Chain in SRUC news:
New appointment to tackle dairy skills crisis
A new role has been created by the Digital Dairy Chain project to re-evaluate how the dairy industry can attract and retain its workforce.
Cumbria’s dairy kitchen opens its doors
A bespoke new food and drink facility has been launched at the Appleby Creamery in Cumbria to support new product development and business growth in the dairy sector.
New partnership to unlock potential of South’s natural economy
SRUC and South of Scotland Enterprise (SOSE) have agreed a ground-breaking partnership which will aim to maximise opportunities presented by the region’s significant and diverse natural resources.
Net-zero Cabinet Secretary sees SRUC climate research in action
Scotland’s Cabinet Secretary for Transport, Net Zero and Just Transition has been learning about some of the cutting-edge climate change research being carried out at SRUC.
Digital Dairy Chain highlighted in National Innovation Strategy
The Principal and Chief Executive of Scotland’s Rural College (SRUC) has welcomed the organisation’s prominent inclusion in Scotland’s newly published National Innovation Strategy.
A toast to £21m Digital Dairy Chain
The South-West of Scotland and Cumbria will become the “go to” region for future investment in high-tech dairy processing.
You may also be interested in:

Dairy Research Centre facilities
Our capacity for research on the nutrition and health of dairy calves and youngstock has expanded in recent years and we are now well equipped to study the lifetime trajectories, health and performance of cows.

Future food systems
Generating knowledge to create safe, sustainable, and new foods chains that deliver healthy diets and support economic growth.

Delivering data & digital innovation
Using data to generate understanding, provide insights, develop and improve products, and increase resource use efficiency across agri-food systems

Food & Enterprise
Whether you are a rural entrepreneur, an SME or multinational, we are passionate about growing your food and drink business.
Find out more about our services

Study with us
With hundreds of courses across more than 20 disciplines, we provide the skills, experience and confidence you need to create a successful career.

Business Services
Our business services work across food supply chains and the natural economy to help clients rise to the challenge of climate change and scientific and technological transformation.

Research
Working with industry and policy makers, our staff and students design, develop and deliver real-world change to benefit the global natural economy.